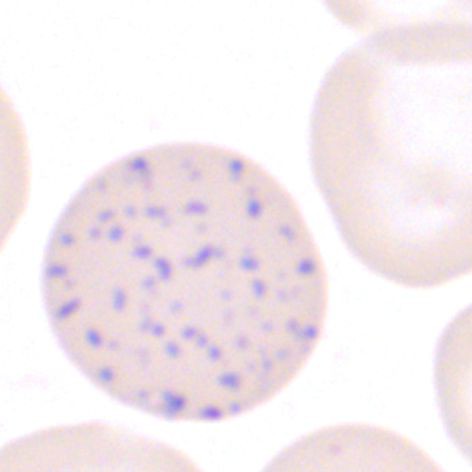

Entstehungsmechanismus
Die RNS-haltige basophile Tüpfelung entsteht durch Denaturierung oder Aggregation von Ribosomen im Zytoplasma des Erythrozyten. Darüber hinaus können außerdem degenerierte Mitochondrien in den basophilen Granula enthalten sein. Die basophile Punktierung ist Ausdruck einer nicht vollständigen Erythrozytenreife oder einer intrazellulären Enzymblockade.
Abb. 1: Blutausstrich, Pappenheim, basophil punktierter Ery | © UK Aachen
Die basophile Tüpfelung ist eine im Blutausstrich nicht selten beschriebene Auffälligkeit, die, wenn sie in kleiner Zahl vorkommt, unspezifisch ist. Finden sich hingegen massenhaft basophil punktierte Erythrozyten kann dies Ausdruck einer sehr seltenen angeborenen hämolytischen Anämie vom Typ Pyrimidin-5-Nukleotidasemangel oder eines erworbenen, toxischen Enzymschadens sein.
Pyrimidin-5-Nukleotidase (P5'N)
P5'N ist ein Enzym, das dem Abbau der Ribonukleinsäure in Erythrozyten dient. Ein Mangel dieses Enzyms bedingt eine Anhäufung von Pyrimidin-Nucleotiden. Im Blutausstrich werden diese als basophile Punktierung sichtbar und bewirken funktionell eine Hemmung der für den Ery-Metabolismus essentiellen Enzyme Pentosephophatase und Ribose-Phosphat-Pyrophosphokinase. Die Folge sind eine gesteigerte Hämolyse und eine Anämie. Der P5'N-Mangel kann angeboren, oder häufiger, erworben sein.
Angeborener P5'N-Mangel
Es handelt sich um eine seltene, autosomal-rezessiv vererbte Erkrankung, charakterisiert durch eine chronische hämolytische Anämie mit prominenter basophiler Punktierung. Außerdem finden sich Targetzellen, Polychromasie, Zeichen extravasaler Hämolyse (Erhöhung von Bilirubin, LDH, Retikulozyten mit Makrozytose der Ery, vermindertes Haptoglobin). Klinisch besteht eine Hepatosplenomegalie.
Vorkommen basophiler Tüpfelung
Wenige basophil getüpfelte Erythrozyten (max. 1 Ery/GF*) können auch bei Blutgesunden auftreten. Ein Anteil von >1/GF ist pathologisch.
Angeborene Erkrankungen mit basophiler Punktierung
- Hereditärer Mangel an Pyrimidin-5-Nukleotidase (massenhaft basophile Tüpfelung)
- Pyruvatkinase-Mangel
- Thalassämie, Minor-, Intermedia- (bes. β-Thalassämie mit Hämoglobin Constant Spring), Major-Form
- Sideroblastische Anämie.
Erworbene Zustände mit basophiler Punktierung
- Schwermetallvergiftung, bes. durch das Enzymgift Blei, aber auch Arsen, Wismut, Silber, Quecksilber
- Megaloblastäre Anämie
- Primäre Myelofibrose
- Myelodysplastisches Syndrom
- Akute myeloische Leukämie, besonders Erythroleukämie
- Lebererkrankungen.
Differenzialdiagnosen
Die basophile Punktierung ist immer gleichmäßig über den gesamten Erythrozyten verteilt. Davon abzugrenzen sind intraerythrozytäre Einschlüsse wie Pappenheimer- und Jolly-Körpcherchen, die fokal im Erythrozyten sichtbar werden. Pappenheimer-Körperchen entsprechen Eisengranula und stellen sich meist membranständig in Gruppen dar. Jolly-Körperchen sind Reste des Erythroblastenkerns, sind von brauner Farbe, größer, erscheinen fast immer solitär und haben eine kreisrunde Form. Vorkommen von Pappenheimer- und Jolly-Körperchen: typischerweise bei Milzlosigeit.
* GF entspricht einem Gesichtsfeld, Vergrößerung Objektiv 100
Literatur
1. Bain J, Huhn D. Roche Grundkurs hämatologische Morphologie, Blackwell Wissenschafts-Verlag, Wien 1997: 66
2. Fuchs R, Staib P, Brümmendorf T et al. Manual Hämatologie, Nora-Verlag, Stolberg 2015: Seiten 59; 206-208; 263
3. Diggs LW, Sturm D, MS A Bell. The morphology of human blood cells. 7 th ed., Abbott 2005.
Der Autor:
Prof. Dr. med. Roland Fuchs
Uniklinik Aachen
Klinik für Hämatologie, Onkologie, Hämostaseologie und Stammzelltransplantation
Die Autorin:
Reinhild Herwartz
Biomedizinische Fachanalytikerin Hämatologie
Uniklinik Aachen, Klinik für Hämatologie, Onkologie, Hämostaseologie und Stammzelltransplantation
E-Mail: reinhild@herwartz.de
Entnommen aus MTA Dialog 11/2015
Dann nutzen Sie jetzt unser Probe-Abonnement mit 3 Ausgaben zum Kennenlernpreis von € 19,90.
Jetzt Abonnent werden
